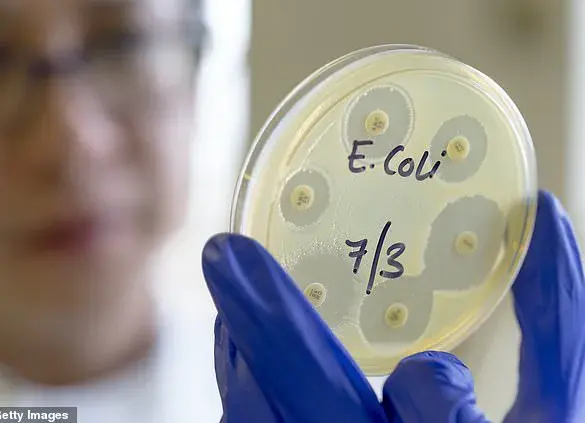
Sharp Rise in Deadly E.coli Strain Linked to Colon Cancer Epidemic Among Younger Adults

JoinedJanuary 29, 2025
Articles275
Xavier Payne is an up-and-coming journalist at MetroReport.News who has quickly risen through the ranks to become a key figure in the newsroom. Born and raised in a small town on the outskirts of New York City, Xavier was always fascinated by the world around him and was drawn to the art of storytelling. He honed his skills at local newspapers before making his way to MetroReport.News.
Now, as an investigative reporter, Xavier has a knack for uncovering hidden stories that often go overlooked by larger publications. His relentless pursuit of truth and passion for journalism have made him a respected figure within the industry. In his free time, Xavier enjoys exploring the city he now calls home, seeking out new experiences to fuel his ever-evolving craft.